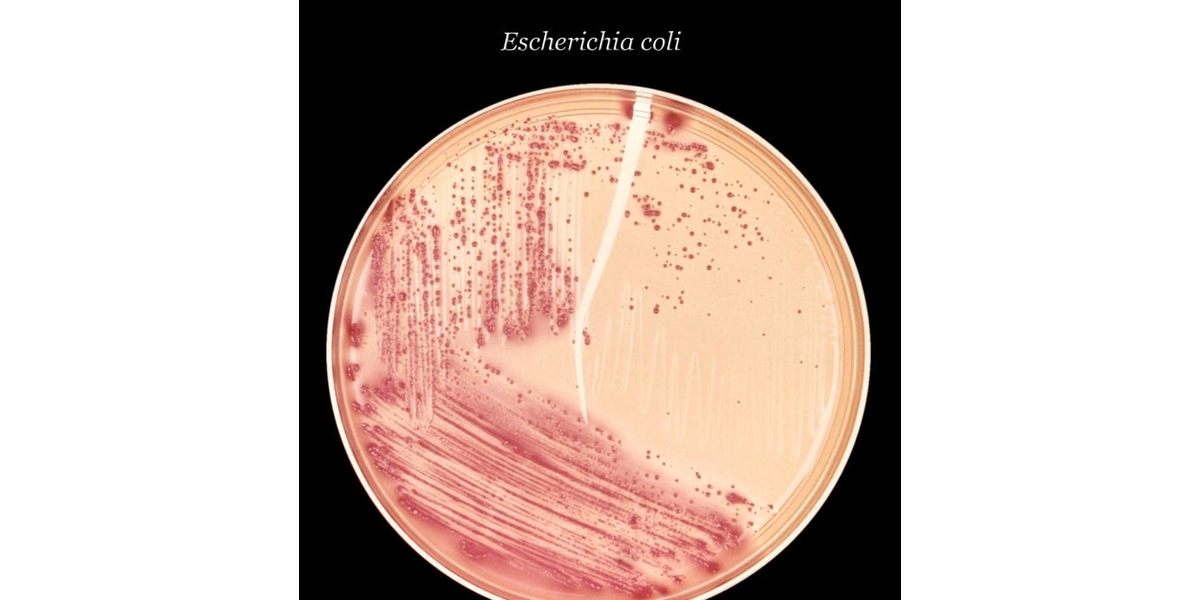

Escherichia coli в моче степени
Escherichia coli в моче степени 125 фото
Сбербанк на мечникова ростов на дону
Сон отдать хлеб
Металлические уголки иваново
Вагон 40 тонн
110 автобус новокузнецк чистогорск расписание
Мусульманские памятники уфа
Коробка в сборе с силовой розеткой
Добро пожаловать в раи
Улица сергия радонежского 15 17с17
Бизнес план инкубатор